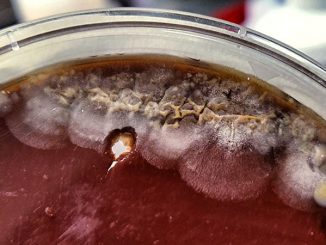

Crunching the numbers: assessing Hungary's reluctance towards entomophagy
For many cultural groups, insects are often not viewed as a desirable food group, but insects can be seen as delicacies in […]
For many cultural groups, insects are often not viewed as a desirable food group, but insects can be seen as delicacies in […] Editor’s note: Find the latest long COVID news and guidance in Medscape’s Long COVID Resource Center. Kate Whitley was petrified […] Recent research has shown that the liver and the brain are closely connected and can affect each other’s functions. So […] Motor vehicles are among the leading causes of death by injury, with the World Health Organization (WHO) reporting that road […] Oasis: Noel Gallagher stars in ‘Return To Rockfield’ trailer At 56 years old, the Wonderwall singer would have begun attending […] Cognitive-behavioral therapy (CBT) may deserve a place alongside ablation and rhythm- and rate-control drugs as a management option for some […] SAN DIEGO – Survodutide, a dual glucagon-like peptide-1 (GLP-1) and glucagon receptor agonist, led to “striking” weight loss in a […] Local authorities should not wait for extreme weather conditions to take action to address homelessness, warn authors of new study […] Australia on Saturday became one of the first countries in the world to allow the use of MDMA and magic […] Topline: Nebulized amphotericin B does not improve exacerbation-free status at 1 year for patients with bronchopulmonary aspergillosis, though it may […]Health News

Crunching the numbers: assessing Hungary's reluctance towards entomophagy

Long COVID Brain Fog Confounds Doctors, but New Research Offers Hope

Dementia and the liver-brain axis: What we know

Study finds nighttime speed limits not effective in reducing e-scooter injuries

Noel Gallagher’s health woes – once told he would ‘drop dead’ coming off meds

Anxiety From AF Symptoms Calmed by Cognitive Training

Survodutide Impresses in Phase 2 Weight-Loss Trial

Hotter temperatures linked to increased risk of hospitalization in Londons homeless population

Australia authorizes MDMA, magic mushrooms for medical treatment
Aspergillosis Status Affected by Nebulized Amphotericin B
Copyright © 2026